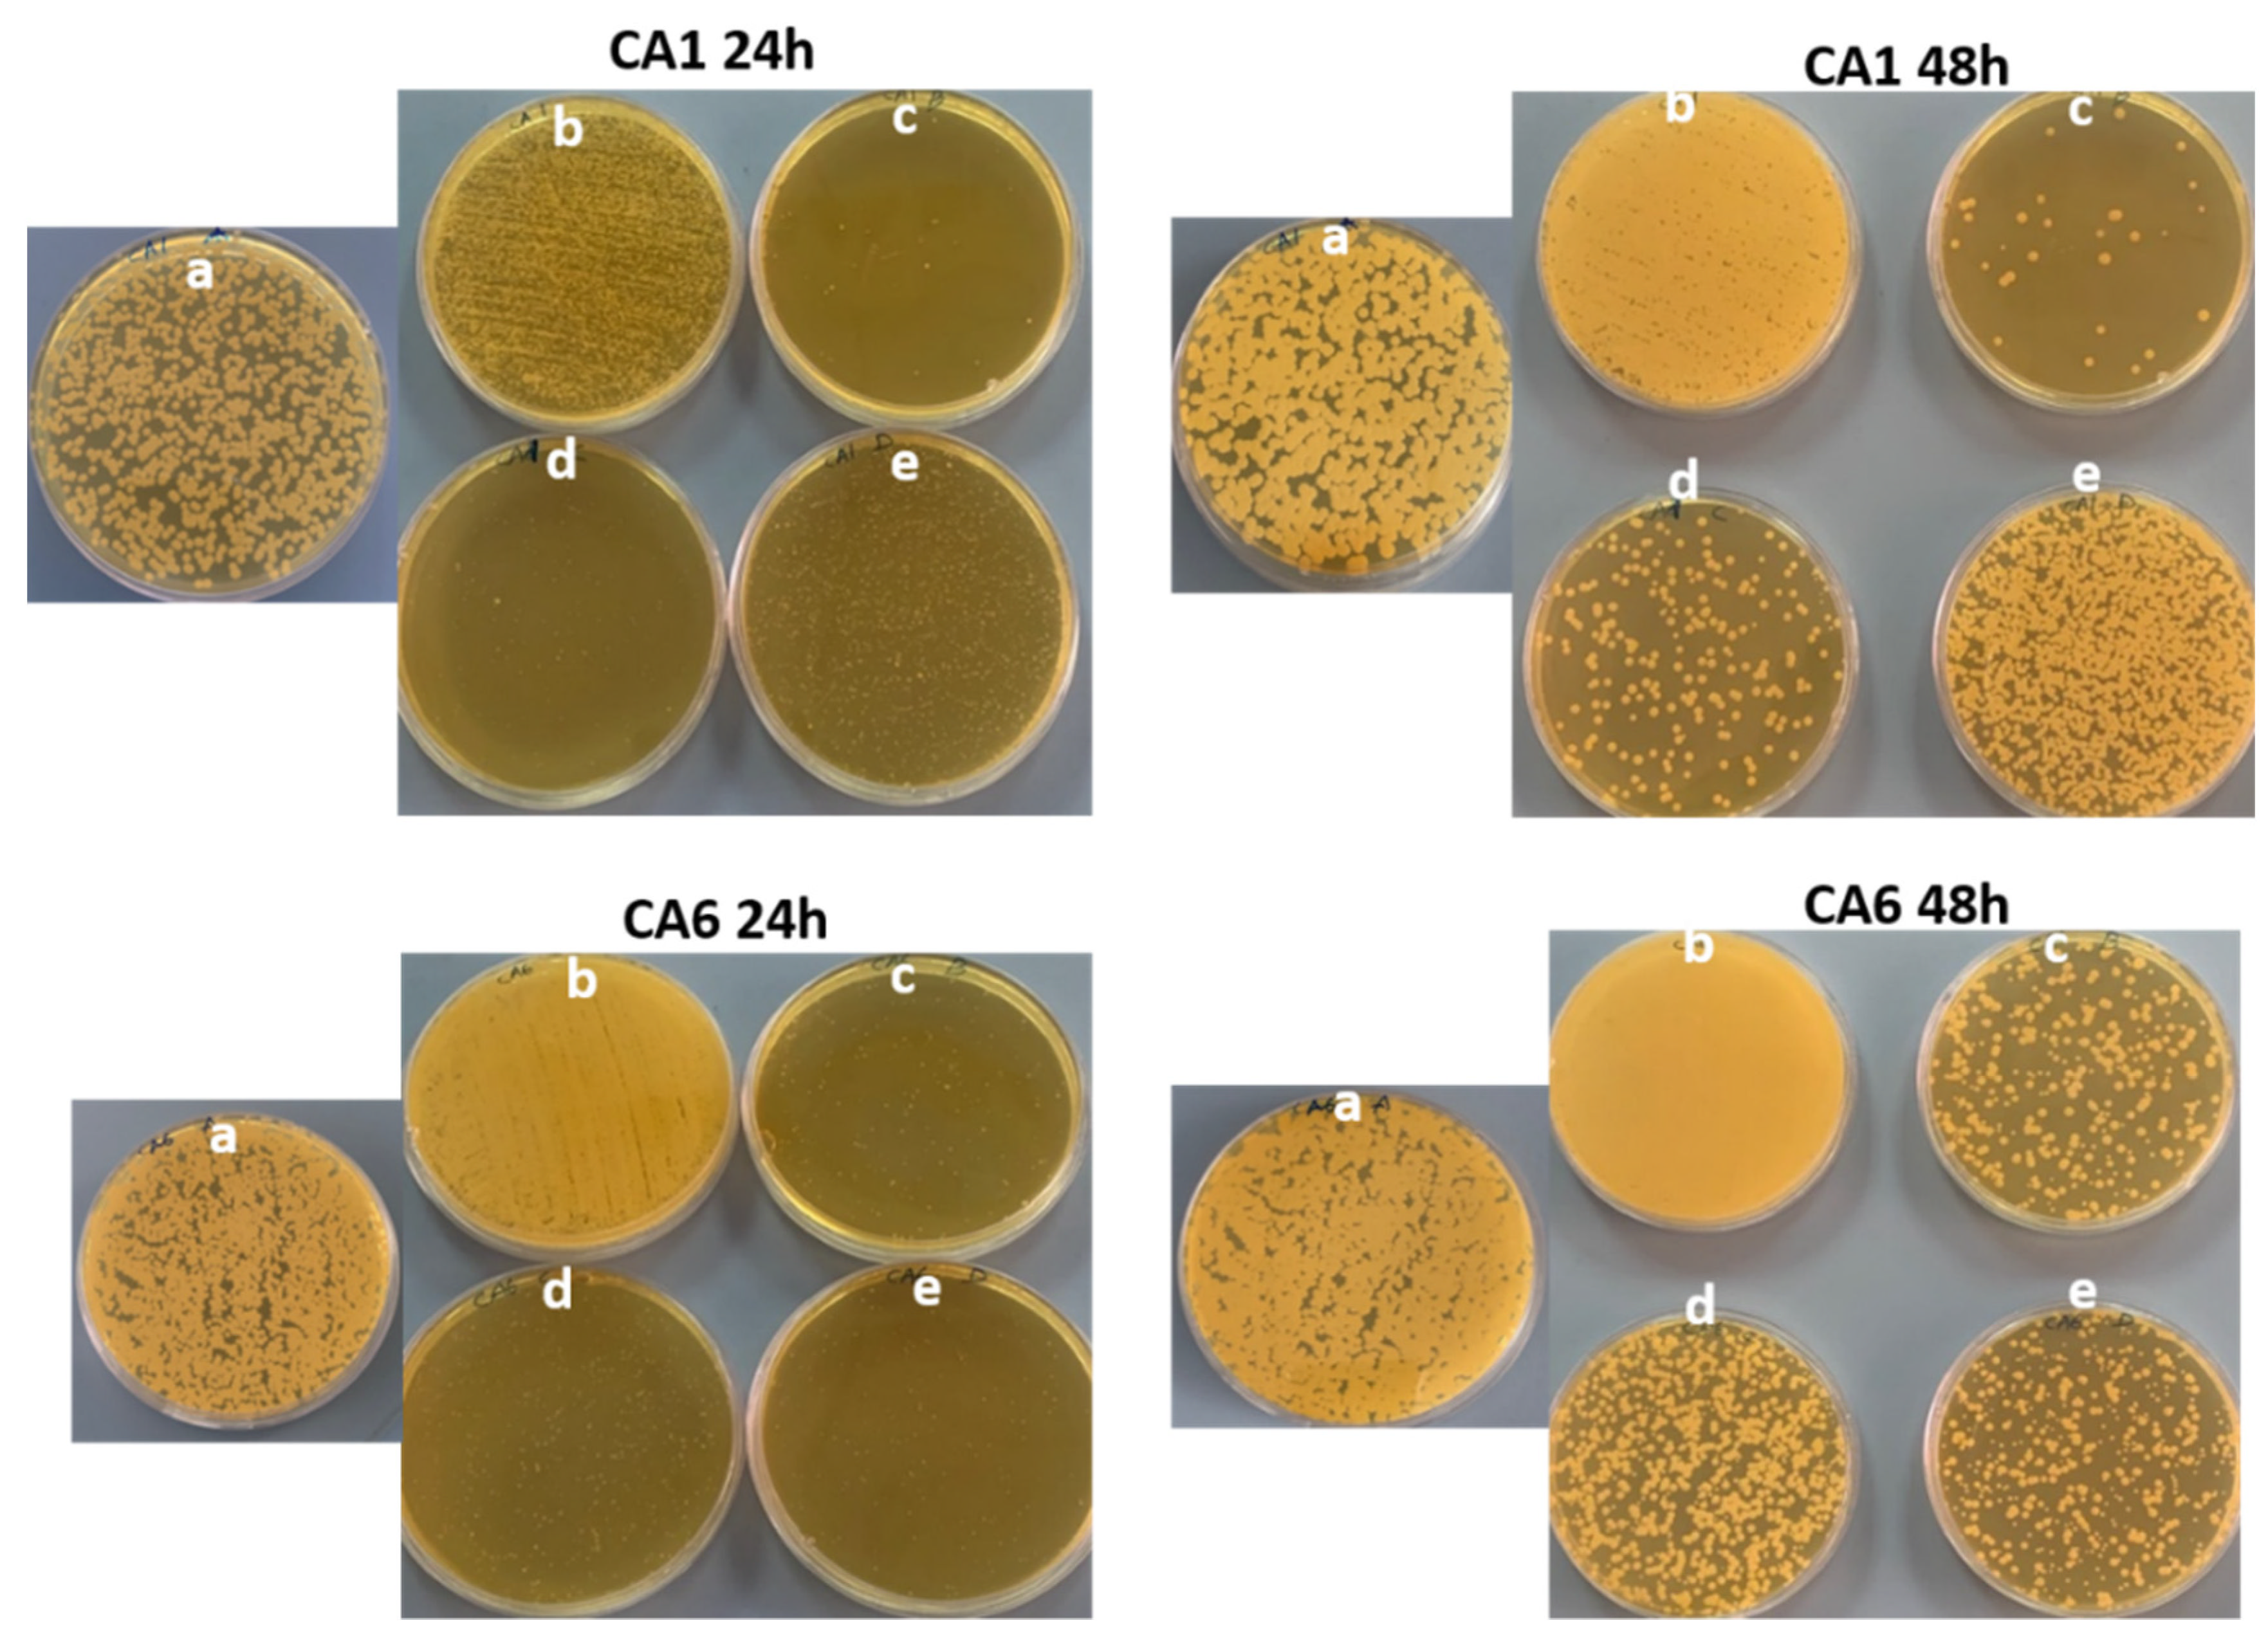
Pharmaceutics 14 02251 g010 Pharmaceutics 14 02251 g010

Therapeutic Intervention for Various Hospital Setting Strains of Biofilm Forming Candida auris with Multiple Drug Resistance Mutations Using Nanomaterial Ag-Silicalite-1 Zeolite
Abstract
1. Introduction
2. Methodology
2.1. Collection and Cultivation of C. auris Strains
2.2. Molecular Identification
2.2.1. DNA Extraction
2.2.2. Amplified of 18S rRNA Gene
2.2.3. Amplified of ITSa and ITSb Regions
2.2.4. Molecular Analysis Resistance-Associated Mutations
2.3. Synthesis of Nanomaterial
2.4. Characterization Analysis of Nanomaterial
2.5. Biofilm Analysis
2.5.1. Cell Kill Analysis
2.5.2. Morphogenesis Genesis by Scanning Electron Microscopy Analysis
2.6. Effect on Planktonic C. auris
3. Results and Discussion
3.1. Molecular Identification of Collected Isolates
3.2. Phylogenetics Based on Its Region
3.3. Drug-Resistance-Associated Mutations
3.3.1. Lanosterol 14-Alpha Demethylase (ERG11)
3.3.2. Zinc-Cluster Transcription Factor-Encoding Gene (TAC1B)
3.3.3. Uracil Phosphoribosyltransferase (FUR1)
3.3.4. Synthesis and Characterization of Synthesized Nanomaterial
3.4. Biofilm Studies
3.5. Morphogenesis Study by SEM
3.6. Effect of Nanocomposite on Planktonic C. auris
4. Conclusions
Supplementary Materials
Author Contributions
Funding
Institutional Review Board Statement
Informed Consent Statement
Data Availability Statement
Acknowledgments
Conflicts of Interest
References
- Baptista, P.V.; McCusker, M.P.; Carvalho, A.; Ferreira, D.A.; Mohan, N.M.; Martins, M.; Fernandes, A.R. Nano-Strategies to Fight Multidrug Resistant Bacteria—“A Battle of the Titans”. Front. Microbiol. 2018, 1, 1441. [Google Scholar] [CrossRef] [PubMed]
- Martins, M.; Mccusker, M.P.; Viveiros, M.; Couto, I.; Fanning, S.; Pagès, J.M.; Amaral, L. A Simple Method for Assessment of MDR Bacteria for Over-Expressed Efflux Pumps. Open. Microbiol. J. 2013, 22, 72–82. [Google Scholar] [CrossRef]
- Mohr, K.I.; Mohr, K.I. History of Antibiotics Research. Curr. Top. Microbiol. Immunol. 2016, 398, 237–272. [Google Scholar] [CrossRef] [PubMed]
- Karaiskos, I.; Lagou, S.; Pontikis, K.; Rapti, V.; Poulakou, G. The “Old’’’ and the ‘New’ “Antibiotics for MDR Gram-Negative Pathogens: For Whom, When, and How. Front. Public Health 2019, 1, 151. [Google Scholar] [CrossRef] [PubMed]
- Khardori, N.; Stevaux, C.; Ripley, K. Antibiotics: From the Beginning to the Future: Part 2. Indian J. Pediatrics 2020, 87, 43–47. [Google Scholar] [CrossRef]
- Mirzaei, B.; Norouzi Bazgir, Z.; Goli, H.R.; Mohammadi, F.; Babaei, R. Prevalence of multi-drug resistant (MDR) and extensively drug-resistant (XDR) phenotypes of Pseudomonas aeruginosa and Acinetobacter baumannii isolated in clinical samples from Northeast of Iran. BMC Res. Notes 2020, 13, 1–6. [Google Scholar] [CrossRef] [PubMed]
- Xavier, D.E.; Pico, R.C.; Girardello, R.; Fehlberg, L.C.C.; Gales, A.C. Efflux pumps expression and its association with porin down-regulation and beta-lactamase production among Pseudomonas aeruginosa causing bloodstream infections in Brazil. BMC Microbiol. 2010, 10, 1–7. [Google Scholar] [CrossRef] [PubMed]
- Fernández, L.; Hancock, R.E.W. Adaptive and mutational resistance: Role of porins and efflux pumps in drug resistance. Clin. Microbiol. Rev. 2012, 25, 661–681. [Google Scholar] [CrossRef]
- Singh, D.P. Efflux Pumps: Warheads of Gram-Negative Bacteria and Efflux Pump Inhibitors. In New Approaches in Biological Research; Nova Science Publishers: New York, NY, USA, 2017; Available online: https://www.researchgate.net/publication/317545061 (accessed on 17 May 2022).
- Association between Biofilm Formation and Antimicrobial Resistance in Carbapenem-Resistant Pseudomonas aeruginosa-PubMed. Available online: https://pubmed.ncbi.nlm.nih.gov/29970441/ (accessed on 18 May 2022).
- Pandey, P.; Sahoo, R.; Singh, K.; Pati, S.; Mathew, J.; Pandey, A.C.; Kant, R.; Han, I.; Choi, E.H.; Dwivedi, G.R.; et al. Drug Resistance Reversal Potential of Nanoparticles/Nanocomposites via Antibiotic’s Potentiation in Multi Drug Resistant P. aeruginosa. Nanomaterials 2021, 12, 117. [Google Scholar] [CrossRef] [PubMed]
- Vergalli, J.; Bodrenko, I.V.; Masi, M.; Moynié, L.; Acosta-Gutierrez, S.; Naismith, J.H.; Davin-Regli, A.; Ceccarelli, M.; Van den Berg, B.; Winterhalter, M.; et al. Porins and small-molecule translocation across the outer membrane of Gram-negative bacteria. Nat. Rev. Microbiol. 2020, 18, 164–176. [Google Scholar] [CrossRef]
- Adegoke, A.A.; Faleye, A.C.; Singh, G.; Stenström, T.A. Antibiotic Resistant Superbugs: Assessment of the Interrelationship of Occurrence in Clinical Settings and Environmental Niches. Molecules 2016, 22, 29. [Google Scholar] [CrossRef] [PubMed]
- Breijyeh, Z.; Jubeh, B.; Karaman, R. Resistance of Gram-Negative Bacteria to Current Antibacterial Agents and Approaches to Resolve It. Molecules 2020, 25, 1340. [Google Scholar] [CrossRef] [PubMed]
- Al-Saggaf, M.S. Nanoconjugation between Fungal Nanochitosan and Biosynthesized Selenium Nanoparticles with Hibiscus sabdariffa Extract for Effectual Control of Multidrug-Resistant Bacteria. J. Nanomater. 2022, 2022, 1–9. [Google Scholar] [CrossRef]
- Munir, M.U.; Ahmad, M.M. Nanomaterials Aiming to Tackle Antibiotic-Resistant Bacteria. Pharmaceutics 2022, 14, 582. [Google Scholar] [CrossRef] [PubMed]
- Aman, S.; Mittal, D.; Shriwastav, S.; Tuli, H.S.; Chauhan, S.; Singh, P.; Sharma, S.; Saini, R.V.; Kaur, N.; Saini, A.K.; et al. Prevalence of multidrug-resistant strains in device associated nosocomial infection and their in vitro killing by nanocomposites. Ann. Med. Surg. 2022, 78, 103687. [Google Scholar] [CrossRef] [PubMed]
- Landis, R.F.; Li, C.H.; Gupta, A.; Lee, Y.W.; Yazdani, M.; Ngernyuang, N.; Altinbasak, I.; Mansoor, S.; Khichi, M.A.; Sanyal, A.; et al. Biodegradable Nanocomposite Antimicrobials for the Eradication of Multidrug-Resistant Bacterial Biofilms without Accumulated Resistance. J. Am. Chem. Soc. 2018, 140, 6176–6182. [Google Scholar] [CrossRef] [PubMed]
- Bradley, S.F. Candida auris Infection. JAMA 2019, 322, 1526. [Google Scholar] [CrossRef] [PubMed]
- Du, H.; Bing, J.; Hu, T.; Ennis, C.L.; Nobile, C.J.; Huang, G. Candida auris: Epidemiology, biology, antifungal resistance, and virulence. PLoS Pathog. 2020, 16, e1008921. [Google Scholar] [CrossRef] [PubMed]
- Sardi, J.D.C.O.; Silva, D.R.; Mendes-Giannini, M.J.S.; Rosalen, P.L. Candida auris: Epidemiology, risk factors, virulence, resistance, and therapeutic options. Microb. Pathog. 2018, 125, 116–121. [Google Scholar] [CrossRef]
- Sarma, S.; Upadhyay, S. Current perspective on emergence, diagnosis and drug resistance in Candida auris. Infect Drug Resist. 2017, 10, 155–165. [Google Scholar] [CrossRef] [PubMed]
- Francis Borgio, J.; Rasdan, A.S.; Sonbol, B.; Alhamid, G.; Almandil, N.B.; Azeez, S.A. Emerging Status of Multidrug-Resistant Bacteria and Fungi in the Arabian Peninsula. Biology 2021, 10, 1144. [Google Scholar] [CrossRef]
- Černáková, L.; Roudbary, M.; Brás, S.; Tafaj, S.; Rodrigues, C.F. Candida auris: A Quick Review on Identification, Current Treatments, and Challenges. Int. J. Mol. Sci. 2021, 22, 4470. [Google Scholar] [CrossRef] [PubMed]
- Hanson, B.M.; Dinh, A.Q.; Tran, T.T.; Arenas, S.; Pronty, D.; Gershengorn, H.B.; Ferreira, T.; Arias, C.A.; Shukla, B.S. Candida auris invasive infections during a COVID-19 case surge. Antimicrob. Agents Chemother. 2021, 65, e01146-21. [Google Scholar] [CrossRef]
- Chakrabarti, A.; Sood, P. On the emergence, spread and resistance of Candida auris: Host, pathogen and environmental tipping points. J. Med. Microbiol. 2021, 7, 001318. [Google Scholar] [CrossRef]
- Jackson, B.R.; Chow, N.; Forsberg, K.; Litvintseva, A.P.; Lockhart, S.R.; Welsh, R.; Vallabhaneni, S.; Chiller, T. On the Origins of a Species: What Might Explain the Rise of Candida auris? J. Fungi 2019, 5, 58. [Google Scholar] [CrossRef] [PubMed]
- Parra-Giraldo, C.M.; Valderrama, S.L.; Cortes-Fraile, G.; Garzón, J.R.; Ariza, B.E.; Morio, F.; Linares-Linares, M.Y.; Ceballos-Garzón, A.; de la Hoz, A.; Hernandez, C.; et al. First report of sporadic cases of Candida auris in Colombia. Int. J. Infect. Dis. 2018, 69, 63–67. [Google Scholar] [CrossRef]
- Frías-De-León, M.G.; Hernández-Castro, R.; Vite-Garín, T.; Arenas, R.; Bonifaz, A.; Castañón-Olivares, L.; Acosta-Altamirano, G.; Martínez-Herrera, E. Antifungal Resistance in Candida auris: Molecular Determinants. Antibiotics 2020, 9, 568. [Google Scholar] [CrossRef] [PubMed]
- Spivak, E.S.; Hanson, K.E. Candida auris: An emerging fungal pathogen. J. Clin. Microbiol. 2018, 56, e01588-17. [Google Scholar] [CrossRef] [PubMed]
- Bruno, M.; Kersten, S.; Bain, J.M.; Jaeger, M.; Rosati, D.; Kruppa, M.D.; Lowman, D.W.; Rice, P.J.; Graves, B.; Ma, Z.; et al. Transcriptional and functional insights into the host immune response against the emerging fungal pathogen Candida auris. Nat. Microbiol. 2020, 5, 1516–1531. [Google Scholar] [CrossRef] [PubMed]
- Sharma, C.; Kumar, N.; Meis, J.F.; Pandey, R.; Chowdhary, A. Draft Genome Sequence of a Fluconazole-Resistant Candida auris Strain from a Candidemia Patient in India. Genome Announc. 2015, 3, e00722-15. [Google Scholar] [CrossRef] [PubMed]
- Sharma, C.; Kumar, N.; Pandey, R.; Meis, J.F.; Chowdhary, A. Whole genome sequencing of emerging multidrug resistant Candida auris isolates in India demonstrates low genetic variation. New Microbes New Infect. 2016, 13, 77–82. [Google Scholar] [CrossRef] [PubMed]
- Nagaraj, S.; Manivannan, S.; Narayan, S. Potent antifungal agents and use of nanocarriers to improve delivery to the infected site: A systematic review. J. Basic Microbiol. 2021, 61, 849–873. [Google Scholar] [CrossRef]
- Curto, M.Á.; Butassi, E.; Ribas, J.C.; Svetaz, L.A.; Cortés, J. Natural products targeting the synthesis of β(1,3)-D-glucan and chitin of the fungal cell wall. Existing drugs and recent findings. Phytomedicine 2021, 88, 153556. [Google Scholar] [CrossRef] [PubMed]
- Sanglard, D.; Ischer, F.; Koymans, L.; Bille, J. Amino acid substitutions in the cytochrome P-450 lanosterol 14alpha-demethylase (CYP51A1) from azole-resistant Candida albicans clinical isolates contribute to resistance to azole antifungal agents. Antimicrob. Agents Chemother. 1998, 42, 241–253. [Google Scholar] [CrossRef] [PubMed]
- Puri, N.; Krishnamurthy, S.; Habib, S.; Hasnain, S.E.; Goswami, S.K.; Prasad, R. CDR1, a multidrug resistance gene from Candida albicans, contains multiple regulatory domains in its promoter and the distal AP-1 element mediates its induction by miconazole. FEMS Microbiol. Lett. 1999, 180, 213–219. [Google Scholar] [CrossRef]
- Li, D.; Wang, Y.; Hu, W.; Chen, F.; Zhao, J.; Chen, X.; Han, L. Application of Machine Learning Classifier to Candida auris Drug Resistance Analysis. Front. Cell. Infect. Microbiol. 2021, 11. [Google Scholar] [CrossRef] [PubMed]
- Whaley, S.G.; Berkow, E.L.; Rybak, J.M.; Nishimoto, A.T.; Barker, K.S.; Rogers, P.D. Azole Antifungal Resistance in Candida albicans and Emerging Non-albicans Candida Species. Front. Microbiol. 2017, 7, 2173. [Google Scholar] [CrossRef] [PubMed]
- Cortegiani, A.; Misseri, G.; Fasciana, T.; Giammanco, A.; Giarratano, A.; Chowdhary, A. Epidemiology, clinical characteristics, resistance, and treatment of infections by Candida auris. J. Intensive Care 2018, 6, 69. [Google Scholar] [CrossRef] [PubMed]
- Lockhart, S.R.; Etienne, K.A.; Vallabhaneni, S.; Farooqi, J.; Chowdhary, A.; Govender, N.P.; Colombo, A.L.; Calvo, B.; Cuomo, C.A.; Desjardins, C.A.; et al. Simultaneous Emergence of Multidrug-Resistant Candida auris on 3 Continents Confirmed by Whole-Genome Sequencing and Epidemiological Analyses. Clin. Infect. Dis. 2017, 64, 134–140. [Google Scholar] [CrossRef] [PubMed]
- Rybak, J.M.; Muñoz, J.F.; Barker, K.S.; Parker, J.E.; Esquivel, B.D.; Berkow, E.L.; Lockhart, S.R.; Gade, L.; Palmer, G.E.; White, T.C.; et al. Mutations in TAC1B: A novel genetic determinant of clinical fluconazole resistance in Candida auris. MBio 2020, 11, e00365-20. [Google Scholar] [CrossRef] [PubMed]
- Rhodes, J.; Abdolrasouli, A.; Farrer, R.A.; Cuomo, C.A.; Aanensen, D.M.; Armstrong-James, D.; Fisher, M.C.; Schelenz, S. Genomic epidemiology of the UK outbreak of the emerging human fungal pathogen Candida auris. Emerg Microbes Infect. 2018, 7, 43. [Google Scholar] [CrossRef] [PubMed]
- Marena, G.D.; Ramos, M.A.D.S.; Lima, L.C.; Chorilli, M.; Bauab, T.M. Galleria mellonella for systemic assessment of anti-Candida auris using amphotericin B loaded in nanoemulsion. Sci. Total Environ. 2021, 807, 151023. [Google Scholar] [CrossRef] [PubMed]
- Chowdhary, A.; Sharma, C.; Meis, J.F. Candida auris: A rapidly emerging cause of hospital-acquired multidrug-resistant fungal infections globally. PLoS Pathog. 2017, 13, e1006290. [Google Scholar] [CrossRef] [PubMed]
- Kamli, M.R.; Srivastava, V.; Hajrah, N.H.; Sabir, J.S.; Hakeem, K.R.; Ahmad, A.; Malik, M.A. Facile Bio-Fabrication of Ag-Cu-Co Trimetallic Nanoparticles and Its Fungicidal Activity against Candida auris. J. Fungi 2021, 7, 62. [Google Scholar] [CrossRef] [PubMed]
- Vazquez-Munoz, R.; Lopez, F.D.; Lopez-Ribot, J.L. Silver Nanoantibiotics Display Strong Antifungal Activity Against the Emergent Multidrug-Resistant Yeast Candida auris Under Both Planktonic and Biofilm Growing Conditions. Front. Microbiol. 2020, 11, 1673. [Google Scholar] [CrossRef]
- Tekin, R.; Bac, N. Antimicrobial behavior of ion-exchanged zeolite X containing fragrance. Microporous Mesoporous Mater. 2016, 234, 55–60. [Google Scholar] [CrossRef]
- Kaali, P.; Strömberg, E.; Aune, R.E.; Czél, G.; Momcilovic, D.; Karlsson, S. Antimicrobial properties of Ag+ loaded zeolite polyester polyurethane and silicone rubber and long-term properties after exposure to in-vitro ageing. Polym Degrad Stab. 2010, 95, 1456–1465. [Google Scholar] [CrossRef]
- Ferreira, L.; Guedes, J.F.; Almeida-Aguiar, C.; Fonseca, A.M.; Neves, I.C. Microbial growth inhibition caused by Zn/Ag-Y zeolite materials with different amounts of silver. Colloids Surfaces B Biointerfaces 2016, 142, 141–147. [Google Scholar] [CrossRef]
- Chavez-Esquivel, G.; Cervantes-Cuevas, H.; Ybieta-Olvera, L.F.; Castañeda Briones, M.T.; Acosta, D.; Cabello, J. Antimicrobial activity of graphite oxide doped with silver against Bacillus subtilis, Candida albicans, Escherichia coli, and Staphylococcus aureus by agar well diffusion test: Synthesis and characterization. Mater. Sci. Eng. C 2021, 123, 111934. [Google Scholar] [CrossRef]
- Vidoni, A.; Ravikovitch, P.I.; Afeworki, M.; Calabro, D.; Deckman, H.; Ruthven, D. Adsorption of CO2 on high silica MFI and DDR zeolites: Structural defects and differences between adsorbent samples. Microporous Mesoporous Mater. 2020, 294, 109818. [Google Scholar] [CrossRef]
- Rehman, S.; Farooq, R.; Jermy, R.; Mousa Asiri, S.; Ravinayagam, V.; Al Jindan, R.; Alsalem, Z.; Shah, M.A.; Reshi, Z.; Sabit, H.; et al. A Wild Fomes fomentarius for Biomediation of One Pot Synthesis of Titanium Oxide and Silver Nanoparticles for Antibacterial and Anticancer Application. Biomolecules 2020, 10, 622. [Google Scholar] [CrossRef] [PubMed]
- Cleare, L.G.; Li, K.L.; Abuzeid, W.M.; Nacharaju, P.; Friedman, J.M.; Nosanchuk, J.D. NO Candida auris: Nitric Oxide in Nanotherapeutics to Combat Emerging Fungal Pathogen Candida auris. J. Fungi 2020, 6, 85. [Google Scholar] [CrossRef] [PubMed]
- Lara, H.H.; Romero-Urbina, D.G.; Pierce, C.; Lopez-Ribot, J.L.; Arellano-Jiménez, M.J.; Jose-Yacaman, M. Effect of silver nanoparticles on Candida albicans biofilms: An ultrastructural study. J. Nanobiotechnol. 2015, 13, 1–12. [Google Scholar] [CrossRef] [PubMed]
- Rehman, S.; Almessiere, M.A.; Tashkandi, N.; Baykal, A.; Slimani, Y.; Jermy, R.; Ravinayagam, V.; Yaman, C. Fabrication of Spinel Cobalt Ferrite (CoFe2O4) Nanoparticles with Unique Earth Element Cerium and Neodymium for Anticandidal Activities. ChemistrySelect. 2019, 4, 14329–14334. [Google Scholar] [CrossRef]
- Widayat, W.; Annisa, A.N. Synthesis and Characterization of ZSM-5 Catalyst at Different Temperatures. IOP Conf. Ser. Mater. Sci. Eng. 2017, 214, 012032. [Google Scholar] [CrossRef]
- Fanning, S.; Mitchell, A.P. Fungal Biofilms. PLOS Pathog. 2012, 8, e1002585. [Google Scholar] [CrossRef]
- Kean, R.; Delaney, C.; Sherry, L.; Borman, A.; Johnson, E.M.; Richardson, M.D.; Rautemaa-Richardson, R.; Williams, C.; Ramage, G. Transcriptome Assembly and Profiling of Candida auris Reveals Novel Insights into Biofilm-Mediated Resistance. mSphere 2018, 3, 00334-18. [Google Scholar] [CrossRef]
- Zhang, J.F.; Rehman, S.; Alghamdi, T.; Sheikh, F.A.; Hassan, M.S.; Amna, T. Bionanotechnology Approaches to Combat Biofilms and Drug Resistance. In Innovative Approaches for Nanobiotechnology in Healthcare Systems; Amna, T., Hassan, M.S., Eds.; IGI Global: Hershey, PA, USA, 2022; pp. 230–248. [Google Scholar] [CrossRef]
- Baran, A.; Fırat Baran, M.; Keskin, C.; Hatipoğlu, A.; Yavuz, Ö.; İrtegün Kandemir, S.; Adican, M.T.; Rovshan, K.; Mammadova, A.; Ahmadian, E.; et al. Investigation of antimicrobial and cytotoxic properties and specification of silver nanoparticles (AgNPs) Derived from Cicer arietinum L. green leaf extract. Front. Bioeng. Biotechnol. 2022, 855136. [Google Scholar] [CrossRef]
- Keskin, C.; Baran, A.; Baran, M.F.; Hatipoğlu, A.; Adican, M.T.; Atalar, M.N.; Huseynova, I.; Khalilov, R.; Ahmadian, E.; Yavuz, Ö.; et al. Green Synthesis, Characterization of Gold Nanomaterials using Gundelia tournefortii Leaf Extract, and Determination of Their Nanomedicinal (Antibacterial, Antifungal, and Cytotoxic) Potential. J. Nanomater. 2022, 2022, 7211066. [Google Scholar] [CrossRef]
- Kwon, Y.J.; Shin, J.H.; Byun, S.A.; Choi, M.J.; Won, E.J.; Lee, D.; Lee, S.Y.; Chun, S.; Lee, J.H.; Choi, H.J.; et al. Candida auris Clinical Isolates from South Korea: Identification, Antifungal Susceptibility, and Genotyping. J. Clin. Microbiol. 2019, 57. [Google Scholar] [CrossRef]
- AlJindan, R.; AlEraky, D.M.; Mahmoud, N.; Abdalhamid, B.; Almustafa, M.; AbdulAzeez, S.; Borgio, J.F. Drug Resistance-Associated Mutations in ERG11 of Multidrug-Resistant Candida auris in a Tertiary Care Hospital of Eastern Saudi Arabia. J. Fungi 2020, 7, 18. [Google Scholar] [CrossRef] [PubMed]
- Li, J.; Coste, A.T.; Liechti, M.; Bachmann, D.; Sanglard, D.; Lamoth, F. Novel ERG11 and TAC1b mutations associated with azole resistance in candida auris. Antimicrob Agents Chemother. 2021, 65, e02663-20. [Google Scholar] [CrossRef] [PubMed]

| Strain No. | F132Y | K143R | K152K |
|---|---|---|---|
| CA1 | +ve | +ve | +ve |
| CA2 | +ve | +ve | - |
| CA3 | +ve | +ve | - |
| CA4 | +ve | +ve | - |
| CA5 | +ve | +ve | - |
| CA6 | +ve | +ve | - |
| CA7 | +ve | +ve | - |
| CA8 | +ve | +ve | - |
| CA9 | +ve | +ve | - |
| CA10 | +ve | +ve | - |
| CA11 | +ve | +ve | - |
| CA12 | +ve | +ve | - |
| CA13 | +ve | +ve | - |
| CA14 | +ve | +ve | +ve |
| CA15 | +ve | +ve | - |
| CA16 | +ve | +ve | - |
| CA17 | +ve | +ve | - |
| CA18 | +ve | +ve | - |
| CA19 | +ve | +ve | - |
| Silent Variants | Missense Variants | |||||
|---|---|---|---|---|---|---|
| Strain No. | G534G | Y584Y | F585F | H608Y | P611S | A640V |
| CA1 | +ve | +ve | +ve | +ve | +ve | +ve |
| CA2 | +ve | +ve | +ve | +ve | +ve | +ve |
| CA3 | +ve | +ve | +ve | +ve | +ve | +ve |
| CA4 | +ve | +ve | +ve | +ve | +ve | +ve |
| CA5 | +ve | +ve | +ve | +ve | +ve | +ve |
| CA6 | +ve | +ve | +ve | +ve | +ve | +ve |
| CA7 | +ve | +ve | +ve | +ve | +ve | +ve |
| CA8 | +ve | +ve | +ve | +ve | +ve | +ve |
| CA9 | +ve | +ve | +ve | +ve | +ve | -ve |
| CA10 | +ve | +ve | +ve | +ve | +ve | +ve |
| CA11 | +ve | +ve | +ve | +ve | +ve | +ve |
| CA12 | +ve | +ve | +ve | +ve | +ve | +ve |
| CA13 | +ve | +ve | +ve | +ve | +ve | +ve |
| CA14 | +ve | +ve | +ve | +ve | +ve | +ve |
| CA15 | +ve | +ve | +ve | +ve | +ve | +ve |
| CA16 | +ve | +ve | +ve | +ve | +ve | +ve |
| CA17 | +ve | +ve | +ve | +ve | +ve | +ve |
| CA18 | +ve | +ve | +ve | +ve | +ve | +ve |
| CA19 | +ve | +ve | +ve | +ve | +ve | +ve |
| Sample Code | Surface Area (SA) (m2/g) | t-Plot MicroSA (m2/g) | MesoSA (m2/g) | Pore Volume (cm3/g) | t-Plot MV (cm3/g) | MesoPV (cm3/g) | PSD (nm) |
|---|---|---|---|---|---|---|---|
| TiZSM-5 | 329 | 161 | 168 | 0.29 | 0.08 | 0.21 | 3.55 |
| 4 wt%Ag/TiZSM-5 | 267 | 131 | 136 | 0.26 | 0.07 | 0.19 | 3.97 |
| Ag-silicalite-1 | 338 | 215 | 123 | 0.21 | 0.10 | 0.11 | 2.51 |
Publisher’s Note: MDPI stays neutral with regard to jurisdictional claims in published maps and institutional affiliations. |
© 2022 by the authors. Licensee MDPI, Basel, Switzerland. This article is an open access article distributed under the terms and conditions of the Creative Commons Attribution (CC BY) license (https://creativecommons.org/licenses/by/4.0/).
Share and Cite
Aldossary, H.A.; Rehman, S.; Jermy, B.R.; AlJindan, R.; Aldayel, A.; AbdulAzeez, S.; Akhtar, S.; Khan, F.A.; Borgio, J.F.; Al-Suhaimi, E.A. Therapeutic Intervention for Various Hospital Setting Strains of Biofilm Forming Candida auris with Multiple Drug Resistance Mutations Using Nanomaterial Ag-Silicalite-1 Zeolite. Pharmaceutics 2022, 14, 2251. https://doi.org/10.3390/pharmaceutics14102251
Aldossary HA, Rehman S, Jermy BR, AlJindan R, Aldayel A, AbdulAzeez S, Akhtar S, Khan FA, Borgio JF, Al-Suhaimi EA. Therapeutic Intervention for Various Hospital Setting Strains of Biofilm Forming Candida auris with Multiple Drug Resistance Mutations Using Nanomaterial Ag-Silicalite-1 Zeolite. Pharmaceutics. 2022; 14(10):2251. https://doi.org/10.3390/pharmaceutics14102251
Chicago/Turabian StyleAldossary, Hanan A., Suriya Rehman, B. Rabindran Jermy, Reem AlJindan, Afra Aldayel, Sayed AbdulAzeez, Sultan Akhtar, Firdos Alam Khan, J. Francis Borgio, and Ebtesam Abdullah Al-Suhaimi. 2022. "Therapeutic Intervention for Various Hospital Setting Strains of Biofilm Forming Candida auris with Multiple Drug Resistance Mutations Using Nanomaterial Ag-Silicalite-1 Zeolite" Pharmaceutics 14, no. 10: 2251. https://doi.org/10.3390/pharmaceutics14102251
APA StyleAldossary, H. A., Rehman, S., Jermy, B. R., AlJindan, R., Aldayel, A., AbdulAzeez, S., Akhtar, S., Khan, F. A., Borgio, J. F., & Al-Suhaimi, E. A. (2022). Therapeutic Intervention for Various Hospital Setting Strains of Biofilm Forming Candida auris with Multiple Drug Resistance Mutations Using Nanomaterial Ag-Silicalite-1 Zeolite. Pharmaceutics, 14(10), 2251. https://doi.org/10.3390/pharmaceutics14102251










